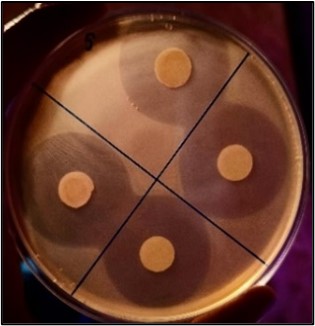

Unter dem Motto „Mach dir einen Kopf“ fand der Regionalwettbewerb Hessen Bergstraße von „Jugend forscht – Schüler experimentieren“ am 3. Februar 2024 erneut bei der BASF Lampertheim GmbH statt. Von den insgesamt 26 eingereichten Projekten waren allein acht vom MakerLab. Keine der anderen teilnehmenden Schulen oder außerschulischen Lernorte kam auch nur annähernd an diese Rekordzahl heran. Vier der MakerLab Projekte erhielten in ihrer Kategorie den ersten Platz und kommen damit weiter in den Landeswettbewerb. Hinzu kamen vier Sonderpreise und ein Forschungspraktikum.
Unter dem Motto „Mach dir einen Kopf“ fand der Regionalwettbewerb Hessen Bergstraße von „Jugend forscht – Schüler experimentieren“ am 3. Februar 2024 erneut bei der BASF Lampertheim GmbH statt. Von den insgesamt 26 eingereichten Projekten waren allein acht vom MakerLab. Keine der anderen teilnehmenden Schulen oder außerschulischen Lernorte kam auch nur annähernd an diese Rekordzahl heran. Vier der MakerLab Projekte erhielten in ihrer Kategorie den ersten Platz und kommen damit weiter in den Landeswettbewerb. Hinzu kamen vier Sonderpreise und ein Forschungspraktikum.
 „Bin ich froh, dass ich eine graue Kurzhaarfrisur habe, dann können mir beim Trampolinspringen nicht die Haare zu Berge stehen“, so Stefan Zimmer, der Antonia Grüdl und Franziska Küch für ihr Projekt „Elektrisierende Haare - Untersuchungen zur elektrischen Leitfähigkeit von Melanin“ den Sonderpreis für Projekte zur Förderung der Gesundheit von Kindern und Jugendlichen überreichte. Die beiden Schülerinnen isolierten Melanin aus Haaren und stellten es parallel synthetisch her, um dessen elektrische Leitfähigkeit In der fotosensibilisierten Solarzelle zu untersuchen. Sie konnten zeigen, dass Melanin eine Leerlaufspannung liefert, die achtmal höher ist als der derzeitige Standard-Farbstoff aus Hibiskus. Damit gewannen beide Schülerinnen im Bereich Chemie in der jüngeren Kategorie „Schüler experimentieren“ und fahren zum Landeswettbewerb in Kassel. Außerdem haben Antonia und Franziska ein Patent angemeldet.
„Bin ich froh, dass ich eine graue Kurzhaarfrisur habe, dann können mir beim Trampolinspringen nicht die Haare zu Berge stehen“, so Stefan Zimmer, der Antonia Grüdl und Franziska Küch für ihr Projekt „Elektrisierende Haare - Untersuchungen zur elektrischen Leitfähigkeit von Melanin“ den Sonderpreis für Projekte zur Förderung der Gesundheit von Kindern und Jugendlichen überreichte. Die beiden Schülerinnen isolierten Melanin aus Haaren und stellten es parallel synthetisch her, um dessen elektrische Leitfähigkeit In der fotosensibilisierten Solarzelle zu untersuchen. Sie konnten zeigen, dass Melanin eine Leerlaufspannung liefert, die achtmal höher ist als der derzeitige Standard-Farbstoff aus Hibiskus. Damit gewannen beide Schülerinnen im Bereich Chemie in der jüngeren Kategorie „Schüler experimentieren“ und fahren zum Landeswettbewerb in Kassel. Außerdem haben Antonia und Franziska ein Patent angemeldet.
Den gleichen Sonderpreis erhielten Amy Hardman und Rosie Holmes für ihr Projekt „DRINKsafe - Rohypnol-Test im Handumdrehen“ sowie den zweiten Platz im Bereich „Arbeitswelt/Sicherheit“ in der Kategorie „Jugend forscht“. Die Schülerinnen haben für Rohypnol, das als K.O. Tropfen für das Spiken von Drinks in Diskotheken verwendet wird, einen Schnelltest entwickelt. Dieser kann unauffällig und anwendungssicher am Handgelenk getragen werden und damit präventiv Missbrauch verhindern. Für ihre Entwicklung haben beide Schülerinnen ein Patent angemeldet.
Im gleichen Wettbewerb starteten auch Maren Teltschick und Theo Kipper mit ihrem Projekt „Werkstoff aus Algen - auf der Suche nach einer Alternative“. Sie haben sich mit der Salzwasseralge Microchloropsis salina beschäftigt. Als Pflanze speichert sie beim Wachstum ziemlich genau die Menge an Kohlenstoffdioxid, die bei der Verbrennung ihrer Trockenbiomasse wieder freigesetzt wird. Dadurch könnte sie ein klimaneutraler Ausgangstoff für neue Werkstoffe sein. „Wir haben der Algen-Trockenmasse verschiedene Mengen von Quarzsand und Naturlatex beigemischt, um das Material dann auf Wärmeleitung, Wärmedämmung, Brennbarkeit, Säure- und Temperaturbeständigkeit zu testen“, so Maren. „Zwei unserer Gemische erreichten in der Wärmeleitung fast die gleichen Werte wie Beton-Estrich, waren jedoch im Gegensatz dazu feuchtigkeitsabweisend.“ Um Aussagen darüber zu treffen, ob sich der Werkstoff als Ersatz für Estrich in Fußbodenheizungen anbietet, sind weitere Tests notwendig. Maren und Theo errangen den dritten Platz und erhielten zudem ein einwöchiges Forschungspraktikum bei der BASF in Ludwigshafen. „Bakterien auf dem Speiseplan - Untersuchungen zur bakteriziden Wirkung von Phagen auf (Antibiotika-resistente) Bakterien“ heißt das Projekt von Misha Hedge und Mia Maurer, die beide im Bereich „Biologie“ in der Kategorie „Schüler experimentieren“ angetreten sind. Die Todesraten aufgrund von Antibiotikaresistenzen steigen Jahr für Jahr, sodass ein Umdenken in der Therapie von bakteriellen Infektionen vonnöten ist. Die Lösung kommt aus der Natur: Viren, die ausschließlich Bakterien, und hier auch nur ganz bestimme Arten, befallen und abtöten. Die beiden Jungforscherinnen haben das Bakterium E. coli 613 erfolgreich mit dem T4 Phagen infiziert. Es gelang ihnen, ein eigenes Phagenlysat herzustellen und dessen Titer zu bestimmen. Antibiotikatests zeigten für Ampicillin, Amoxicillin und Equibactin deutliche Hemmhöfe des Bakterienstamms. Ihr Projekt erhielt den ersten Platz und damit ebenfalls die Fahrt zum Landeswettbewerb in Kassel.
„Bakterien auf dem Speiseplan - Untersuchungen zur bakteriziden Wirkung von Phagen auf (Antibiotika-resistente) Bakterien“ heißt das Projekt von Misha Hedge und Mia Maurer, die beide im Bereich „Biologie“ in der Kategorie „Schüler experimentieren“ angetreten sind. Die Todesraten aufgrund von Antibiotikaresistenzen steigen Jahr für Jahr, sodass ein Umdenken in der Therapie von bakteriellen Infektionen vonnöten ist. Die Lösung kommt aus der Natur: Viren, die ausschließlich Bakterien, und hier auch nur ganz bestimme Arten, befallen und abtöten. Die beiden Jungforscherinnen haben das Bakterium E. coli 613 erfolgreich mit dem T4 Phagen infiziert. Es gelang ihnen, ein eigenes Phagenlysat herzustellen und dessen Titer zu bestimmen. Antibiotikatests zeigten für Ampicillin, Amoxicillin und Equibactin deutliche Hemmhöfe des Bakterienstamms. Ihr Projekt erhielt den ersten Platz und damit ebenfalls die Fahrt zum Landeswettbewerb in Kassel.
Tom Lippok trat mit seinem Projekt „RENEWacycle - Klimaneutrale Dekarbonisierung durch CaCl2 Abfallverwertung“ im Bereich Chemie in der Kategorie „Jugend forscht“ an. Er hat sich mit dem Solvay-Verfahren beschäftigt, welches allein im Jahr 2022 weltweit 58 mio. t CaCl2 als Abfallstoff produzierte. In dieser Größenordnung gibt es für CaCl2 keine Verwendung. Tom hat sich daher zum Ziel gesetzt, ein Verfahren zu entwickeln, das unter Dekarbonisierung der Atmosphäre CaCl2 wiederverwertet, einen geschlossenen Ressourcenkreislauf hat, mit erneuerbaren Energien arbeitet und ins Solvay-Verfahren reintegriert werden kann. Dafür erhielt er den ersten Platz sowie den Sonderpreis des VCI Hessen und nimmt am Landeswettbewerb Hessen in Darmstadt teil. Sein Kreislaufverfahren hat Tom ebenfalls zum Patent angemeldet. Diyon Edirimanne, Thom-Joshua Meidinger und Dakshesh Rajesh Pillai haben einen Delta-3D-Drucker gebaut, der mit Ton arbeitet, und dessen Steuerung programmiert. „Wir haben lange probieren müssen, um die richtige Ton-Konsistenz und Druckgeschwindigkeit zu bestimmen, aber genau eine Woche vor dem Wettbewerb gelang uns der erste Mehrschichtdruck“, so Diyon. Ihr Projekt „Eine Schicht nach der anderen“ erhielt im Bereich Technik in der Kategorie „Jugend forscht“ den zweiten Platz.
Diyon Edirimanne, Thom-Joshua Meidinger und Dakshesh Rajesh Pillai haben einen Delta-3D-Drucker gebaut, der mit Ton arbeitet, und dessen Steuerung programmiert. „Wir haben lange probieren müssen, um die richtige Ton-Konsistenz und Druckgeschwindigkeit zu bestimmen, aber genau eine Woche vor dem Wettbewerb gelang uns der erste Mehrschichtdruck“, so Diyon. Ihr Projekt „Eine Schicht nach der anderen“ erhielt im Bereich Technik in der Kategorie „Jugend forscht“ den zweiten Platz.
Die Inspiration für ihr Projekt „Mund-Nasen-Schutzmasken – Schutz für uns, Schaden für die Natur?“ erhielten Charlotte Popp und Clara Tonarelli aus der Tatsache, dass in der Coronazeit medizinische Einwegmasken achtlos in der Natur entsorgt wurden, statt im Restmüll zu landen. Sie konnten zeigen, dass die von ihnen untersuchte, kompostierbare Marie Bee Bloom Maske den Maskenträger vor allen getesteten Keimen genauso schützt wie FFP2- und OP-Masken. Da diese Maske jedoch einen geringen Tragekomfort hat, haben die Schülerinnen ein Maskenmaterial für eine eigene biologisch abbaubare und schützende Maske entwickelt, welches sich auch maskentypisch falten und verkleben lässt. Deren Abbauprozess wollen sie dann im direkten Vergleich zu bereits erhältlichen Masken testen. Dafür haben die beiden ein geschlossenes Kompostiersystem mit automatisierter Produktanalyse entwickelt. Clara und Charlotte erhielten im Bereich Biologie in der Kategorie „Jugend forscht“ den ersten Platz und damit das Ticket zum Landeswettbewerb.
 Das Projekt „UreasekatalyseRETARD - oder wie effektiv senken Urease-Inhibitoren Ammoniakemissionen?“ von Ayana Strauch und Judith Kaffenberger hatte leider das Pech, das in Lampertheim keine Jury für den Bereich Geo/Raum in der Kategorie „Jugend forscht“ existierte. Daher wurden sie dem Bereich Biologie zugeordnet, was jedoch nicht den chemisch-geologischen Grundlagen des Projektes gerecht wurde. Harnstoff, der für die Düngung von Agrarböden verwendet wird, wird mittels des Enzyms Urease im Boden hydrolysiert, was die Synthese gasförmigen Ammoniaks anheizt. Ziel des Projekts war, verschiedene Inhibitoren des Enzyms daraufhin zu prüfen, inwieweit sie diese Synthese effektiv verlangsamen. Um das zu zeigen, haben sie zunächst die Reaktionsgeschwindigkeit der Urease quantifiziert und konnten eine Michaelis-Menten-Konstante ermitteln, die nur geringfügig von dem publizierten Wert für die Urease aus Schwertbohnen abweicht. In Versuchen mit Waldboden stellten sie eine Zunahme des atmosphärischen Ammoniaks fest, sobald sie den pH-Wert des Bodens ins Alkalische verschoben. Zugabe des Urease-Inhibitors Thioharnstoff verlangsamt die Ammoniak-Emission. Die beiden Schülerinnen erhielten den zweiten Platz.
Das Projekt „UreasekatalyseRETARD - oder wie effektiv senken Urease-Inhibitoren Ammoniakemissionen?“ von Ayana Strauch und Judith Kaffenberger hatte leider das Pech, das in Lampertheim keine Jury für den Bereich Geo/Raum in der Kategorie „Jugend forscht“ existierte. Daher wurden sie dem Bereich Biologie zugeordnet, was jedoch nicht den chemisch-geologischen Grundlagen des Projektes gerecht wurde. Harnstoff, der für die Düngung von Agrarböden verwendet wird, wird mittels des Enzyms Urease im Boden hydrolysiert, was die Synthese gasförmigen Ammoniaks anheizt. Ziel des Projekts war, verschiedene Inhibitoren des Enzyms daraufhin zu prüfen, inwieweit sie diese Synthese effektiv verlangsamen. Um das zu zeigen, haben sie zunächst die Reaktionsgeschwindigkeit der Urease quantifiziert und konnten eine Michaelis-Menten-Konstante ermitteln, die nur geringfügig von dem publizierten Wert für die Urease aus Schwertbohnen abweicht. In Versuchen mit Waldboden stellten sie eine Zunahme des atmosphärischen Ammoniaks fest, sobald sie den pH-Wert des Bodens ins Alkalische verschoben. Zugabe des Urease-Inhibitors Thioharnstoff verlangsamt die Ammoniak-Emission. Die beiden Schülerinnen erhielten den zweiten Platz.
Den Sonderpreis „Einladung zum Workshop für Projektbetreuende im Herbst 2024 in Lemgo“ (CTS Gruppen- und Studienreisen) erhielt unser Projektbetreuer Stefan Netzer.
Ein besonderes Dankeschön von allen teilnehmenden Schülerinnen und Schüler sowie allen Projektbetreuerinnen und -betreuer geht an unsere Europaschulkoordinatorinnen Silke Keil und Stephanie Lücke für die Unterstützung unseres MakerLabs aus Europageldern.
Wir als Projektbetreuende sind sehr stolz auf das, was die Jungforscherinnen und Jungforscher geleistet haben. In den Weihnachtsferien haben sie kontinuierlich an ihrer Langfassung geschrieben und sind noch zweimal an die Schule gekommen, um Experimente zu wiederholen. Kaum abgegeben, mussten sie dann in nur zwei Wochen ihre Poster entwerfen und fit für die Präsentation werden. Mit all ihren helfenden Händen war Freitag um 21 Uhr der Bus bis zum Dach bepackt mit den Projektkisten und bereit, um an nächsten Tag zum Wettbewerb nach Lampertheim zu fahren. Weiter so!
Eure Projektbetreuerinnen und Projektbetreuer
Dr. Sara Bosio, Laín Mencía Martínez, Stefan Netzer, Dr. Dietmar Scherr und Dr. Petra Leidert
Text und Fotos: P. Leidert

